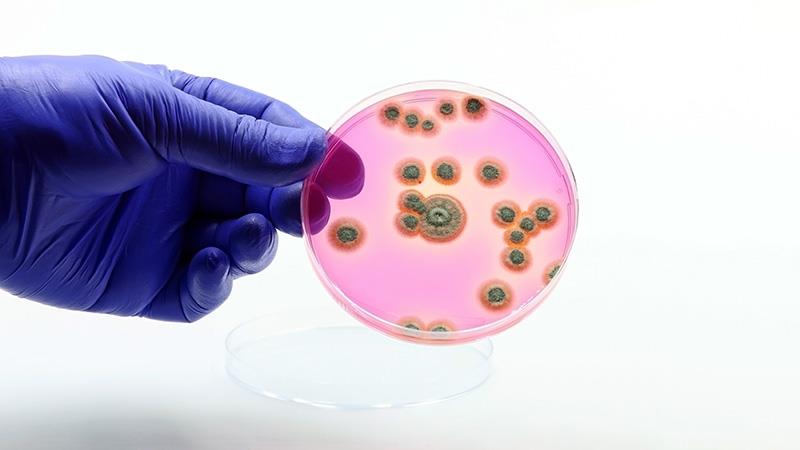

A study conducted at Hospital Ampang reveals insights into the distribution and antifungal susceptibility patterns of Candida species over the period from 2014 to 2015.
The study, published in The Journal of Infection in Developing Countries, found the predominant species isolated was Candida tropicalis, followed closely by Candida albicans. Alarmingly, the study found significant resistance among Candida species to commonly used azoles, particularly itraconazole and fluconazole. However, high susceptibility was observed for amphotericin B, echinocandins (anidulafungin, micafungin, and caspofungin), and flucytosine. [2018;12(2):102–108]
The findings highlight the need for continued surveillance of antifungal resistance patterns. The study recommends routine antifungal susceptibility testing in clinical settings to ensure effective treatment protocols. Additionally, the observed high resistance to azoles calls for cautious use of these antifungal agents, suggesting a preference for echinocandins and amphotericin B in treating invasive Candida infections. The significant association between C. tropicalis infections and underlying hematological disorders also indicates a need for targeted preventive measures in high-risk patient groups.
The retrospective study analyzed yeast infections among patients at Hospital Ampang, a tertiary government hospital and national reference center for hematological disorders. Data were collected from 1 January 2014 to 31 December 31 2015. Yeast isolates were identified through standard culture methods, including germ tube tests, chromogenic agar, and biochemical identification tests.
Antifungal susceptibility testing was performed using the colorimetric microdilution method (Sensititre YeastOne). Minimum inhibitory concentration (MIC) values were interpreted according to Clinical and Laboratory Standards Institute (CLSI) breakpoints. The study analyzed a total of 149 yeast cultures, mainly from blood and respiratory specimens. Statistical analyses were conducted using IBM SPSS Statistics version 24.0, with Pearson’s Chi-squared test determining the significance of associations.
Candida spp are the leading cause of invasive fungal infections worldwide, posing significant morbidity and mortality risks. These opportunistic pathogens, part of the normal human flora, can cause various infections, ranging from superficial to life-threatening systemic diseases. Candida albicans has traditionally been the most common species responsible for invasive candidiasis. However, recent trends indicate an increasing prevalence of non-albicans Candida (NAC) species such as C. tropicalis, C. glabrata, and C. parapsilosis.
The rise in invasive Candida infections is largely attributed to increased use of immunosuppressive therapies, invasive medical devices/procedures, and broad-spectrum antibiotics. Candidemia, a bloodstream infection caused by Candida species, is particularly concerning in hospitalized patients with underlying conditions, especially those with hematological disorders. [J Antimicrob Chemother 2023;78(7):1569–1585]
Effective management of invasive candidiasis relies heavily on timely and appropriate antifungal therapy. The Infectious Diseases Society of America (IDSA) recommends echinocandins as the first-line treatment for candidemia in both neutropenic and non-neutropenic patients. Despite this, fluconazole remains widely used due to its cost-effectiveness and availability.
However, the emergence of antifungal resistance, particularly to azoles, is a critical issue. Resistance patterns vary globally, necessitating local surveillance to guide treatment strategies. The findings highlight the urgent need for targeted antifungal stewardship to combat rising resistance trends and ensure optimal patient outcomes.
Note: While this is an older study, a recent abstract appearing in the May issue of Medical Journal of Malaysia, reflect similar findings, where the majority of candidemia cases were attributed to the more resistant NAC species. [https://www.e-mjm.org/2024/v79s2/PP-05.pdf] While C. albicans continued to be susceptible to antifungal agents, C. glabrata and C. tropicalis exhibited significant resistance to triazoles. The researchers suggest that echinocandins should be considered as an initial treatment for NAC infections, particularly in high-risk patients, until antifungal susceptibility test results are available.